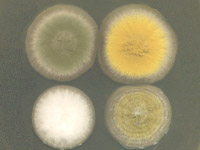

Moulds around Us
Unfortunately, most moulds grow very well at the same temperatures that humans prefer. In addition, anyone who has cleaned out their refrigerator quickly realized that temperatures close to freezing are not cold enough to prevent mould growth and temperatures that are much warmer than humans prefer, like those of the tropics, will grow abundant quantites of mould. Therefore, growth in our home environment through the control of temperatures.

Mould composed of long filaments called hyphae. Mould hyphae grow over the surface and inside nearly all substances of plant or animal origin. All of us are exposed to some moulds every day with no dab effects. We may breath in mould spores that are present in the air or eat foods in which mould has begun to grow, but mould-related allergenic and asthmatic conditions in homes are very common and could be very serious, and should be not ignored. Nearly fungi(moulds) cause a wide variety of diseases and infections, specially in persons with severely compromised immune system, seniours, babies, mother-to-be, small kids, people with astma-like symthoms hystory also in the high-rick group.
Immediate Attention Moulds
| Mould | Found on | Clinical Syndromes | |
|---|---|---|---|
Aspergillus spp. |
carpets, wallpaper, drywall, wood, basement, bathrooms, kitchen and soil | Hay fever, Asthma, Humidifier lung, Malt worker's lung, Compost lung, Wood trimmer's disease, Straw hypersensitivity, Farmer's lung, Oat grain hypersensitivity, others. |  |
Alternaria sp. |
wide variety of substrates from carpets and window frames to soil and plants | Hay fever, Asthma, Humidifier lung, Compost lung, Wood trimmer's disease, Straw hypersensitivity, Farmer's lung, nasal and subcutaneous lesions, infections in immunocompromised individuals. Major plant pathogens. Alternaria spp. have emerged as opportunistic pathogens particularly in patients with immunosuppression, such as the bone marrow transplant patientsans and AIDS patiens. |  |
Candida albicans |
naturally lives in each gastrointestinal track, mucous membranes and on the skin | When our body's ecosystem becomes imbalanced Candida overgrowth can occur thus allowing it to attack ant organ or system in our body. |  |
Chaetomium spp. |
carpets, wood mattresses, soil, air, and plant debris | Hay fever, Asthma, rare cause of nail infections, brain abscess and peritonitis. |  |
Cladosporium spp. |
textiles, window sills, wood, kitchen, bathroom and basement, capable of growing on refrigerated foods | Hay fever, Asthma, Humidifier lung, Malt worker's lung, Compost lung, Wood trimmer's disease, Straw hypersensitivity, Farmer's lung, Oat grain hypersensitivity, others. |  |
Fusarium spp. |
wallpaper and in the basement, requires very wet condition | Hay fever, Asthma, cause of mycotic eye infections, keratitis, onychomycosis, mycetoma, and disseminated infection in immunocompromised patients, can also cause root rot and seedling blight. |  |
Penicillium sp. |
carpets, wood, mattressess, in the basement and on food | Penicillium has been isolated from patients with keratitis, pneumonia, endocarditis, peritonitis, and urinary tract infections. Most Penicillium infections are encountered in immunosuppressed hosts. Penicillium marneffei infection, so called penicilliosis marneffei, is acquired via inhalation and results in initial pulmonary infection. The lymphatic system, liver, spleen and bones are usually involved. Acne-like skin papules on face, trunk, and extremities are observed during the course of the disease. |  |
Scopulariopsis sp. |
wallpaper, carpets and wood | Skin lesions, mycetoma, invasive sinusitis, keratitis, endophthalmitis, pulmonary infections, endocarditis, brain abscess and disseminated infections due to Scopulariopsis spp. have been reported. Invasive Scopulariopsis infections are seen mainly in immunocompromised hosts, such as bone marrow transplant recipients. |  |
| Stachybotrys chartarum (the black mould)  |
contaminated grains, tobacco, insulator foams, wallpaper, carpets, basement, drywall, wood, indoor air and water-damaged buildings | Stomatitis, rhinitis, conjunctivitis, pancytopenia and neurological disorders developed in animals following ingestion of hay contaminated with Stachybotrys. |  |
Toronto & York Region Mould Inspection Services
